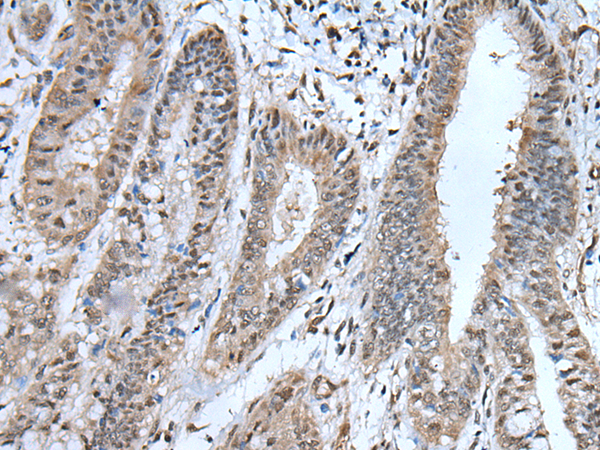
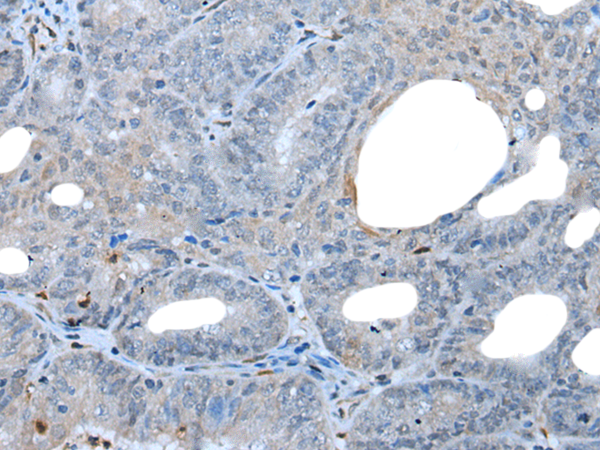

-
分类: 科研抗体货号: P12920别名: UNC5H1应用: WB,IHC反应种属: Human, Mouse, Rat
-
分类: 科研抗体货号: P12904别名: PHGDHL1应用: WB,IHC反应种属: Human, Mouse
-
分类: 科研抗体货号: P12919别名: UNC5H2; p53RDL1应用: IHC反应种属: Human, Mouse, Rat
-
分类: 科研抗体货号: P12903别名: L40; CEP52; RPL40; HUBCEP52应用: IHC反应种属: Human, Mouse, Rat
-
分类: 科研抗体货号: P12918别名: ATG1B; Unc51.2应用: IHC反应种属: Human, Mouse
-
分类: 科研抗体货号: P12902别名: GPA34; dJ889N15.1; 1700062D20Rik应用: IHC反应种属: Human, Mouse, Rat
-
分类: 科研抗体货号: P12917别名: CGT; UGT4应用: IHC反应种属: Human, Mouse, Rat
-
分类: 科研抗体货号: P12901别名: EAP45; C13orf9; CGI-145应用: WB,IHC反应种属: Human, Mouse, Rat
-
分类: 科研抗体货号: P12916别名: HLUG4; UGT2B8; UDPGTH3; UDPGT 2B8; UDPGT2B15应用: IHC反应种属: Human
-
分类: 科研抗体货号: P12900别名: MEM3; PARK17应用: WB,IHC反应种属: Human, Mouse

鄂公网安备42018502007531号
鄂公网安备42018502007531号

